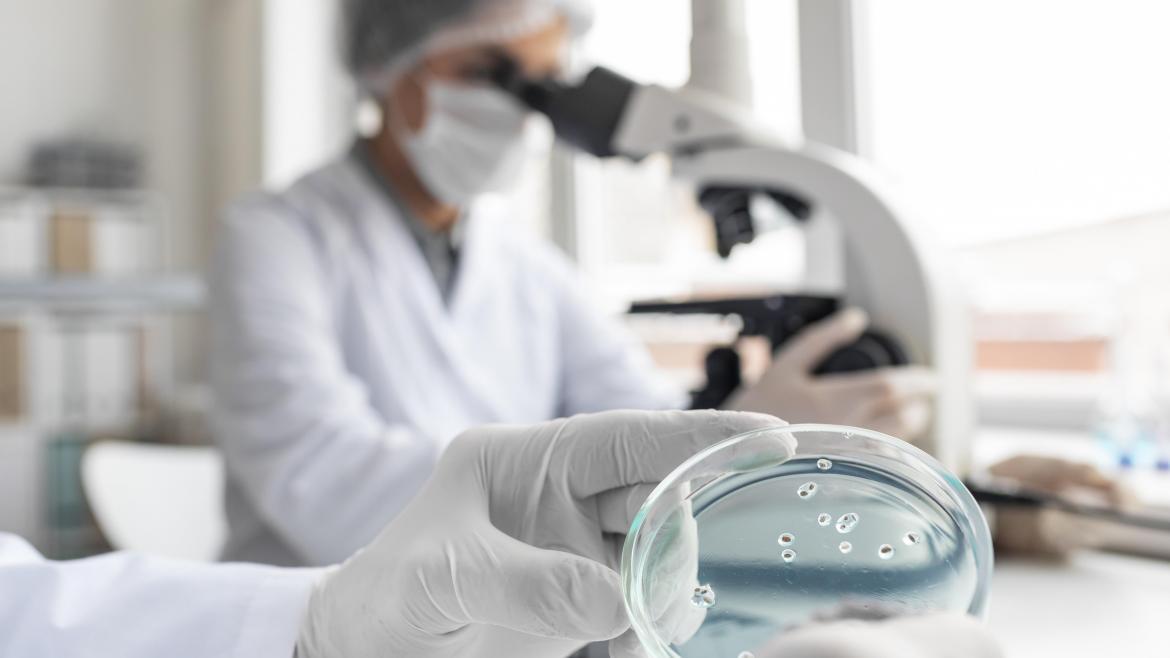

Búsqueda avanzada
Búsqueda avanzada
Filtros
5 Resultados
Desde hasta
Si no encuentras lo que buscas, usa los filtros de búsqueda para afinar la búsqueda y obtener resultados más precisos.
Lunes 16 Junio 20251
El Hospital público de La Princesa organiza un Curso de Actualización en Sepsis e Infección Grave para residentes
Resumen autogenerado por OpenAI
Audios generados (reproducción automática)
Los audios se reproducen de forma automática uno detrás de otro. Haz clic en el icono para descargar el audio o aumentar/disminuir la velocidad de reproducción.
Debido al tamaño del artículo, la generación del audio puede tardar unos segundos y es posible que se generen varios audios para un mismo artículo.
Jueves 20 Marzo 20251
El Hospital público de la Princesa acoge el 'Encuentro multidisciplinar internacional Código Sepsis'
Resumen autogenerado por OpenAI
Audios generados (reproducción automática)
Los audios se reproducen de forma automática uno detrás de otro. Haz clic en el icono para descargar el audio o aumentar/disminuir la velocidad de reproducción.
Debido al tamaño del artículo, la generación del audio puede tardar unos segundos y es posible que se generen varios audios para un mismo artículo.
Jueves 7 Marzo 20241
El Hospital de La Princesa recibe un premio de la Fundación Código Sepsis
Resumen autogenerado por OpenAI
Audios generados (reproducción automática)
Los audios se reproducen de forma automática uno detrás de otro. Haz clic en el icono para descargar el audio o aumentar/disminuir la velocidad de reproducción.
Debido al tamaño del artículo, la generación del audio puede tardar unos segundos y es posible que se generen varios audios para un mismo artículo.
Viernes 3 Noviembre 20231
El Hospital de La Princesa celebra su II Jornada Científica en Enfermería
Resumen autogenerado por OpenAI
Audios generados (reproducción automática)
Los audios se reproducen de forma automática uno detrás de otro. Haz clic en el icono para descargar el audio o aumentar/disminuir la velocidad de reproducción.
Debido al tamaño del artículo, la generación del audio puede tardar unos segundos y es posible que se generen varios audios para un mismo artículo.
Miércoles 25 Octubre 20231
El Hospital de La Princesa imparte la cuarta edición del Curso de Excelencia sobre su Código Sepsis
Resumen autogenerado por OpenAI
Audios generados (reproducción automática)
Los audios se reproducen de forma automática uno detrás de otro. Haz clic en el icono para descargar el audio o aumentar/disminuir la velocidad de reproducción.
Debido al tamaño del artículo, la generación del audio puede tardar unos segundos y es posible que se generen varios audios para un mismo artículo.
0 Resultados
Desde hasta
Si no encuentras lo que buscas, usa los filtros de búsqueda para afinar la búsqueda y obtener resultados más precisos.
Filtros
0 Resultados
Desde hasta
Si no encuentras lo que buscas, usa los filtros de búsqueda para afinar la búsqueda y obtener resultados más precisos.
Filtros